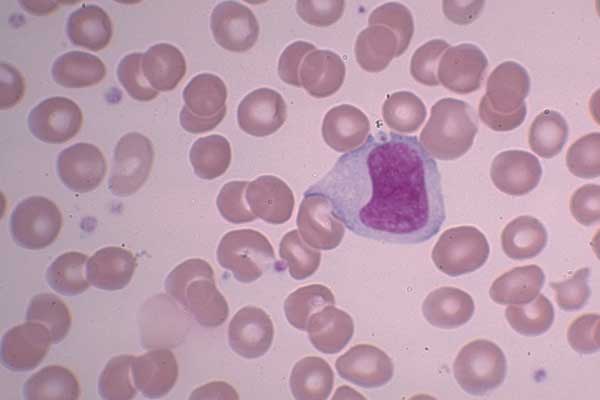

Моноцит фото
Азбука счастливой семьи для родителей
Изготовлю золотые украшения
Жить сначала программа мир
Адата 710
Hermes русский сайт
Клип песни asti
Дзен ют
Какая няша
Срок давности платежей жкх
Pvz fusion mode как поменять язык
Банановые оладьи простой рецепт
Драка между предпринимателями и сотрудниками уфсб
Морцепан это
Моноцит фото 103 фото